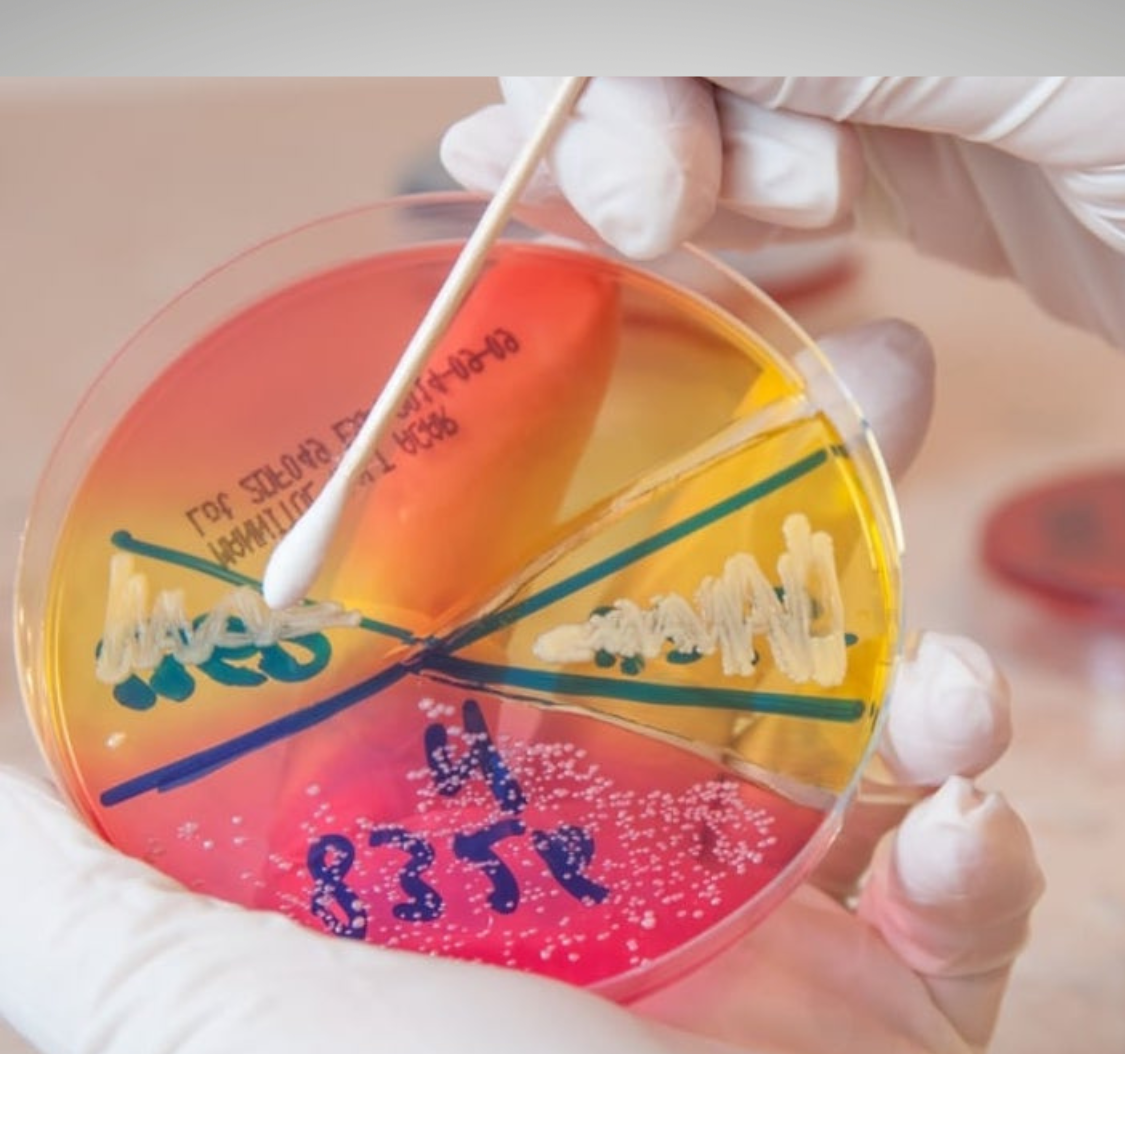

TAMPONE FARINGEO
Verifica sospette infezioni da Streptococchi o altri batteri caratteristici del cavo orale e faringeo e possibile infezione da candida.
60.00€
Aggiungi al carrelloPer l’individuazione di funghi e batteri caratteristici del cavo orale
Con l’analisi del campione raccolto tramite tampone faringeo si rileva l’eventuale presenza di batteri/funghi nella zona del cavo orale, oltre a testare la presenza della candida. Particolarmente indicato per infezioni frequenti e/o recidivanti della zona, spesso causate da stafilococchi, streptococchi o altri batteri patogeni, qualora vi sia rilevazione di patogeni, questi vengono sottoposti ad Aromatogramma, antibiogramma e/o antimicogramma per definire quale olio essenziale o altri principi attivi siano più efficaci per eliminare la carica batterica/micotica.